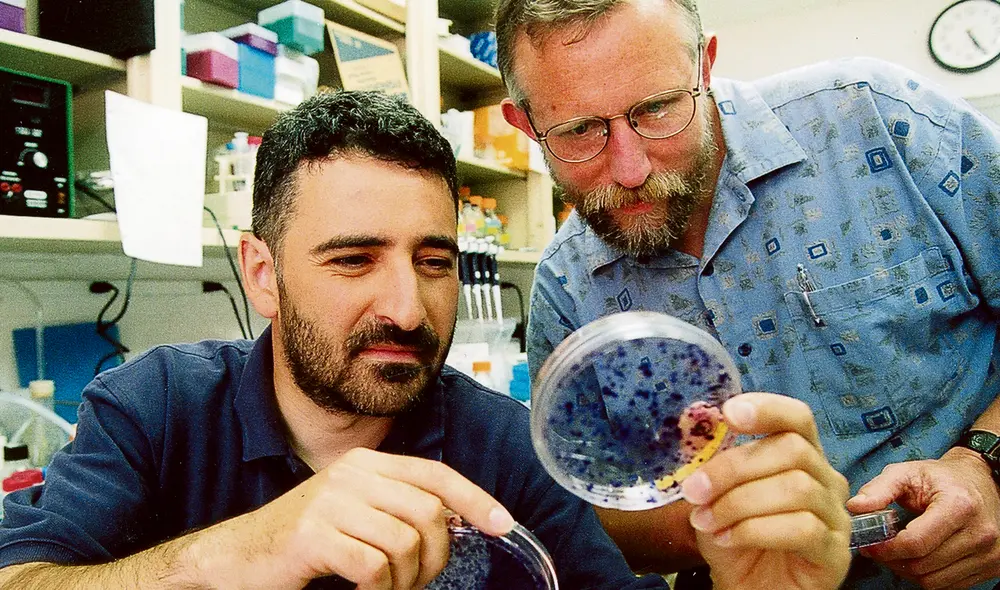
cientificos hepatitis c charles rice cientificos hepatitis c charles rice

Descubridores de la hepatitis C ganan Nobel de Medicina
Premio 2020. Harvey J. Alter, Michael Houghton y Charles M. Rice hallaron el virus de un mal que no tenía explicación. Ayudaron a salvar millones de vidas.
- China desafía a EE.UU. con su oferta de cable submarino a un país de América Latina para dominar su infraestructura digital
- Ranking de la OCDE revela de qué país de América Latina salen más migrantes a países desarrollados: no es Venezuela
Este lunes, el jurado del Instituto Karolinska (Suecia) anunció el Premio Nobel de Medicina 2020 para Harvey J. Alter, Michael Houghton y Charles M. Rice, tres científicos cuyos trabajos ayudaron a identificar al virus de una enfermedad que no tuvo explicación por más de una década: la hepatitis C.
En la década de 1970, ya se había identificado a los virus que causan las hepatitis A y B. Harvey J. Alter, de los Institutos Nacionales de Salud de EEUU, investigaba estos males en pacientes que habían recibido transfusiones de sangre. Muchos pertenecían al tipo B; sin embargo, había un gran número de casos sin identificar. Los pacientes de este grupo desarrollaban el mal crónico, lo que era muy preocupante.
TE RECOMENDAMOS
ÁLVARO PAZ DE LA BARRA EN VIVO Y MIRTHA VÁSQUEZ SE SALVA | ARDE TROYA CON JULIANA OXENFORD
Tras demostrar que la sangre de estos pacientes podía transmitir dicha enfermedad a los chimpancés, las investigaciones de Alter definieron en 1978 una nueva forma de hepatitis crónica transmitida por virus. Y se le conoció como hepatitis “no A, no B”.
Equipos científicos de todo el mundo se embarcaron en la tarea de identificar este nuevo patógeno. A pesar de los esfuerzos, tras más de una década, el agente infeccioso seguía siendo un misterio.
La puerta a una cura
Un equipo liderado por Michael Houghton, quien trabajaba en la farmacéutica Chiron, llevó a cabo una técnica innovadora: creó una colección de fragmentos de ADN a partir de ácidos nucleicos de la sangre de un chimpancé infectado y los comparó con suero de pacientes, que posee anticuerpos contra el virus. Así, los investigadores hallaron una coincidencia de ADN viral.
El estudio posterior, publicado en 1989, mostró que este fragmento se derivó de un nuevo virus de ARN perteneciente a la familia de flavivirus. Lo llamaron virus de la hepatitis C. El patógeno había sido identificado, pero aún no se sabía si era capaz de causar hepatitis por sí solo.
Charles M. Rice, investigador de la Universidad de Washington en St. Louis, junto a otros grupos de investigación, notó una región previamente desconocida en el extremo del genoma del virus. Sospechó que podría ser importante para su replicación. También observó variaciones genéticas en muestras de virus aisladas que podrían dificultar su desarrollo. Con ayuda de ingeniería genética, Rice produjo una variante de ARN del virus de la hepatitis C que incluía la región recién definida y descartaba de las características que lo ‘debilitaban’
Este ARN fue inyectado en el hígado de chimpancés. Luego, detectó virus en la sangre de los primates, que desarrollaron la enfermedad de forma similar a la observada en humanos.
PUEDES VER El calentamiento global está variando las temperaturas nocturnas de otra forma, revela estudio
“Esta fue la prueba final de que el virus de la hepatitis C por sí solo podía causar los casos inexplicables de hepatitis mediada por transfusiones”, sostiene la Asamblea Nobel.
El trabajo de los tres científicos, agrega el ente, permitió disponer de análisis de sangre altamente sensibles para el virus y medicamentos antivirales.
“La enfermedad ahora se puede curar, lo que aumenta las esperanzas de erradicar el virus de la hepatitis C”, concluye.
Hepatitis
Vírica. Es la inflamación del hígado causada principalmente por infecciones virales.
Otras causas. El exceso de alcohol, las toxinas ambientales y las enfermedades autoinmunes también pueden provocar su aparición.
















